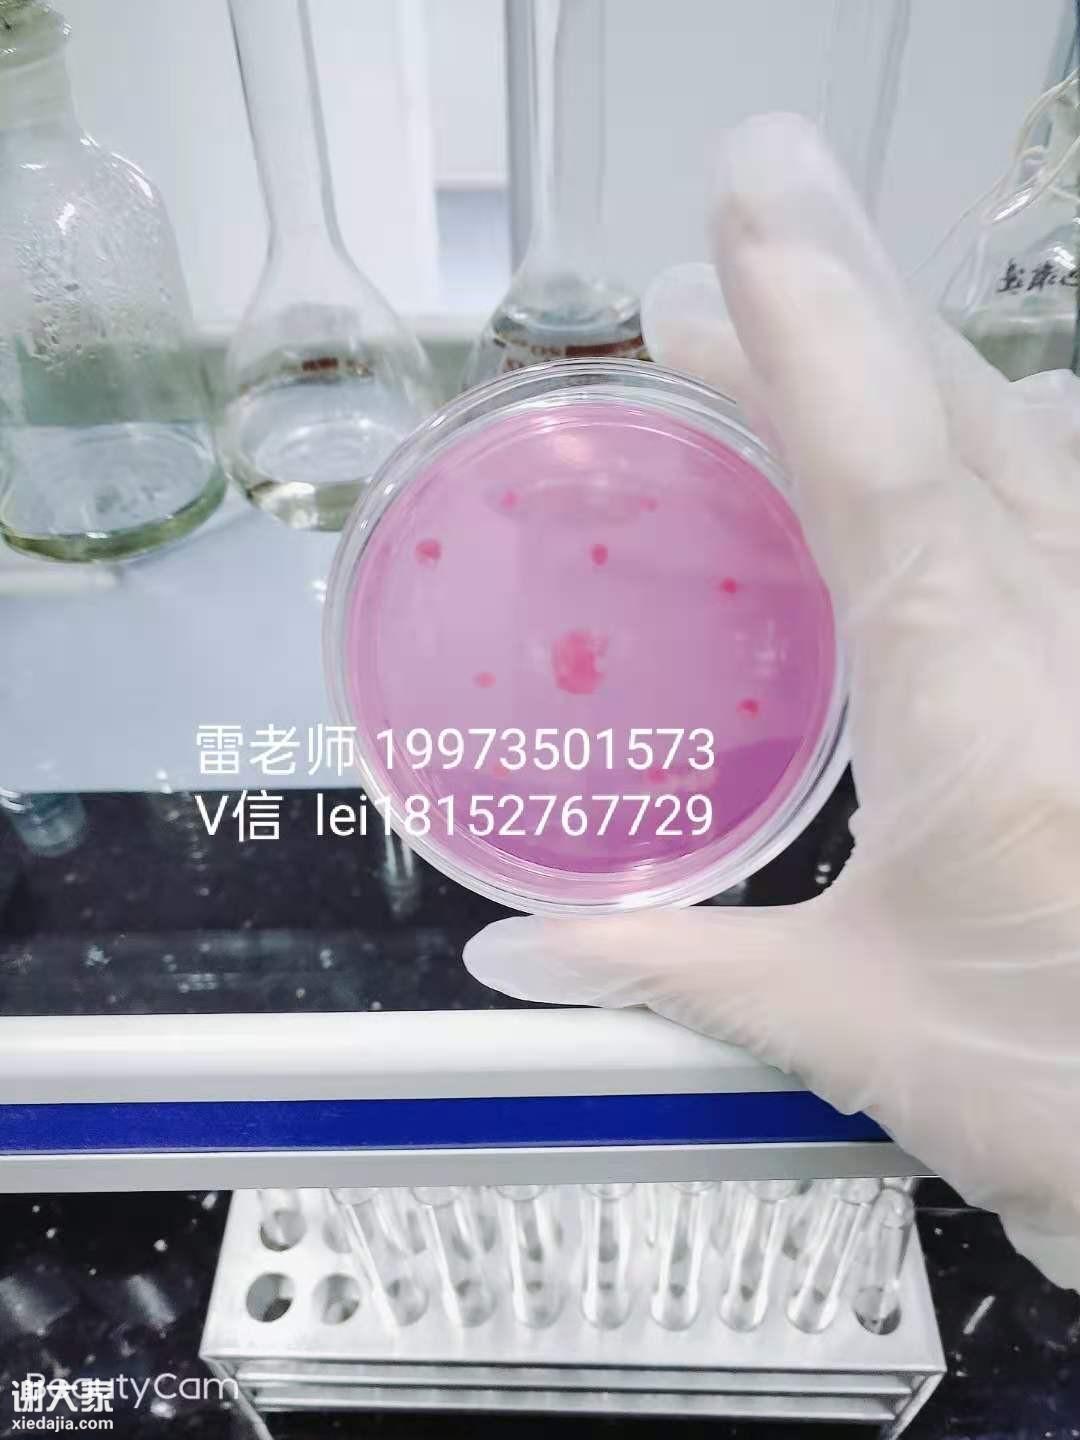

广州化妆品微检验员资格证报名考证,广州圣问技术举办的微检验员,化学检验员,食品检验员,水质检验员,饲料检验员,污水处理员,理化员,等
岗位职责
岗位职责:
1.负责微生物限度检验并出具检验报告。
2.负责包装材料质量检査并出具检验报告。
3.负责工艺用水监测、洁净度监控。
4.负责卫检室现场管理。
5.负责相关岗位操作规程等文件的起草。
6.完成主管临时交办的工作。
培训对象
从事或准备化学检验员,食品检验员,水质检验员,污水检验呀,饲料检验员农产品检验员,产品安全性能检验、产品可靠性能检验、产品环境适应性能检验、贵金属首饰钻石宝玉石检验、纺织纤维检验,无损检测员,质检员,检验员,化验员,物理性材料检验员等,
培训内容
1.实验室安全意识,
2.仪器校准,保养,
3.培养基,溶剂的配置,
4.灭菌锅的安全使用,
5.报表的正确填写,
6.对公司产品,原料,水质,半成品,成品,环境,人员,进行相关的微生物检测
微生物培养掌握
一、菌落总数
菌落总数是指示性微生物指标,并非致病菌指标。主要用来评价食品清洁度,反映食品在生产过程中是否符合卫生要求。
菌落总数超标说明个别企业可能未按要求严格控制生产加工过程的卫生条件,或者包装容器清洗消毒不到位;还有可能与产品包装密封不严,储运条件控制不当等有关。
二、大肠菌群
大肠菌群是国内外通用的食品污染常用指示菌之一。食品中检出大肠菌群,提示被致病菌(如沙门氏菌、志贺氏菌、致病性大肠杆菌)污染的可能性较大。本次检出大肠菌群超标的产品均未检出致病菌,结合居民膳食结构、抽检情况等因素综合分析,健康风险较低,但反映该食品卫生状况不达标。大肠菌群超标可能由于产品的加工原料、包装材料受污染,或在生产过程中产品受人员、工器具等生产设备、环境的污染、
三、霉菌
霉菌超标主要原因可能是原料或包装材料受到霉菌污染,产品在生产加工过程中卫生条件控制不到位,生产工器具等设备设施清洗消毒不到位或产品储运条件不当而导致。
四、霉菌和酵母
霉菌和酵母超标原因可能是加工用原料受霉菌污染,也可能是流通环节抽取的样品霉菌和酵母超标,后者为储运条件控制不当导致。
霉菌和酵母在自然界很常见,霉菌可使食品变质,破坏食品的色、香、味,降低食品的食用价值,本次抽检霉菌和酵母超标的产品未检出真菌毒素、致病菌。
五、铜绿假单胞菌
铜绿假单胞菌是一种条件致病菌,广泛分布于各种水、空气、正常人的皮肤、呼吸道和肠道等,易在潮湿的环境存活,对消毒剂、紫外线等具有较强的抵抗力,对于抵抗力较弱的人群存在健康风险。
天然矿泉水中铜绿假单胞菌超标可能是源水防护不当,水体受到污染;生产过程中卫生控制不严格,如从业人员未经消毒的手直接与矿泉水或容器内壁接触;或者是包装材料清洗消毒有缺陷所致。
考核鉴定分理论考试和技能考核,结业后,颁发农产品食品检验员岗位培训合格证书(证书长期有效,无需年审,全国联网查询,该证书是食品检验人员职业技能水平的资格凭证)。
培训考核收费标准:
1、报考食品检验员,水质检验员,微检验员,理化员等职业技能培训证书费用:初级1800、中级2000、高级2200元/人;
培训安排:
全国各地招生,根据学员报名最近地区安排相关培训,各开班详细上课地址和交通乘坐方式安排于开课前一周统一下发通知给各位报名学员,另企业人数较多可以根据企业需求课程组织内训课程送教上门。
为保证学习质量,每班不超过20人,详细咨询雷老师 199雷7350老1573师